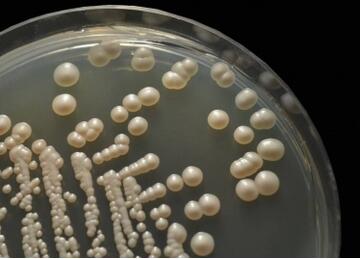
婴儿鹅口疮症状有哪些
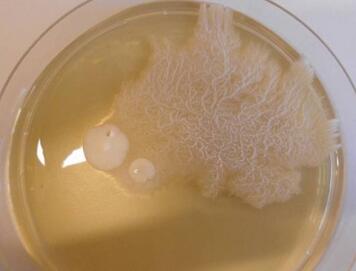
婴儿鹅口疮症状有哪些

[婴儿疾病]用盐水清洗宝宝的鹅口疮有一定的效果,可以使鹅口疮的症状得到缓解,但是不能够使疾病得到根治。婴儿的具体治疗方案需要根据儿童不同的情况来制定不同的治疗方案。年龄较小的儿童可

婴儿鹅口疮症状有哪些?婴儿鹅口疮是怎么回事?你家宝宝嘴里长白毛是鹅口疮吗?今天咱们就讲讲为什么越消毒,越有鹅口疮,怎么根治鹅口疮?
最近,好多家长咨询2,3个月宝宝嘴里长白毛的问题,看了一下发过来的图片,典型的鹅口疮。简单问诊后,发现要么是家里每天消毒好多次,要么就是孩子刚生病完,吃过8,9天抗生素。并且这些宝宝的鹅口疮,有些治疗后,还会反复出现。今天咱们就讲讲为什么越消毒,越有鹅口疮,怎么根治鹅口疮。
如果您宝宝嘴里有下面图片上的表现,那就是鹅口疮。

上图是舌头上的鹅口疮

上图是上颚处的鹅口疮

上图是悬雍垂和嘴唇上的鹅口疮
从上面的图片,可以看出,鹅口疮是出现在面颊内侧、舌头、嘴唇内侧、上颚等处的类似乳凝块样的白色斑片。
为啥叫鹅口疮呢?说是像鹅的嘴巴,晕,给这个病起名字的人,真的很会观察生活啊。

像不像?敢说不像咬你!
●上面看到,鹅口疮比较像奶凝块(奶渍),怎么和奶渍区分呢?
如果是奶渍留在舌头上,多是从胃里反流来的,或者孩子没有咽下去的,这种情况下,奶渍不多,用棉签一刮,非常容易刮掉,刮掉后,是正常的舌头。而鹅口疮是长到舌头或者口腔其他部位的,不容易刮掉;用力刮掉了,会出现下面鲜红的创面。
●那怎么能断定不是白色舌苔呢?
对于小宝宝而言,吃奶次数多,唾液少,不刷牙、不刷舌苔,奶和舌头脱落的上皮细胞容易在舌头上沉积,容易形成白色的舌苔,有些宝宝的舌苔确实比较厚,和鹅口疮也比较像,怎么区分呢?
首先,舌苔比较均匀,不像鹅口疮,这一片,那一片;
第二,舌苔只长在舌头上,多位于舌的中后部,舌尖少见,而鹅口疮在舌头上、嘴唇上,上颚上,嘴巴里到处生长;

上图可见均匀的白色舌苔,舌尖上没有
第三,舌苔比较容易刮下,刮下来的舌苔比较细腻,多有臭味;刮完后,舌头上露出的,可能是下面的一层舌苔,也可能是正常的舌头,鹅口疮用力刮下来后,留下的是鲜红的创面。
第四,舌苔不会让孩子有不适感,而鹅口疮可能会让孩子有不适感,严重的会疼痛。
第五,这是拔高题目,可以不记。母乳和奶粉喂养的宝宝都可能有白舌苔,其中母乳喂养的宝宝,舌苔感觉是白中带蓝,奶粉喂养的宝宝,舌苔更多是黄白色,可能更厚。
多数情况下,鹅口疮不会导致孩子疼痛,也不会导致孩子不愿意吃奶,有些大孩子会说嘴巴里有棉花的感觉,这提示鹅口疮长的挺多。
少数情况下,鹅口疮导致口腔粘膜损伤,会导致孩子疼痛不适,不愿意吃奶。

出现鹅口疮后,因为不止会导致口腔的问题,有可能还会导致消化道内出现症状,导致孩子拉肚子,严重的会有全身的感染问题,导致败血症,脑膜炎,所以需要治疗。
要知道怎么治疗,需要先知道鹅口疮的原因是什么。
鹅口疮是因为口咽部白色念珠菌(也叫白假丝酵母菌)过度生长所引起的,这是真菌感染。正常情况下,白色念珠菌就生存在皮肤、口腔和消化道、泌尿生殖道,但是因为这些地方其他的细菌、病毒非常强势,他们一直被压制着,数量非常少,就不会致病。另外其他细菌病毒虽然多,但已经和身体达成协议,形成稳态,也不会得病。

上图是白色念珠菌的示意图,看着是不是白色的,是不是像念珠一样呢?这是真菌的不感染时的状态,属于酵母相。
上图是白色念珠菌在培养基上培养后形成的酵母样菌落。
上图是白色念珠菌的另外一个形态,叫做菌丝相,这是导致感染的形态。白色念珠菌因为有酵母相,也有菌丝相,被称为白假丝酵母菌。
但是,如果口腔内的其他细菌病毒大量的死亡,那白色念珠菌没有了压制,就会大量的繁殖起来,就会导致出现鹅口疮的症状。这时最常见的情况。
另外,在机体免疫力弱的时候,对各种细菌、病毒、真菌的压制力都弱,这些都增殖起来,白色念珠菌也会增殖,表现出鹅口疮症状,这时,不仅有鹅口疮的问题,还有其他细菌病毒的感染问题哦。
因为你使用的消毒剂,都是针对细菌或病毒的啊,杀不死真菌啊。比如用84拖地,用滴露洗衣服,用含有酒精的手消、湿巾擦手、喂奶前擦拭乳房,这些杀菌剂都会留在这些物体表面。
当孩子在地板上爬,舔地板,舔手,吃奶时,这些杀菌剂就会进入口腔,长期这样,就会把口腔里面的细菌、病毒杀灭,之后,真菌可不就猖獗起来,大量繁殖,表现出鹅口疮了。

地板上的消毒剂,全进嘴啦
治疗很简单啊,杀死白色念珠菌就行啦。下面就是杀死他们的方法:
1.制霉菌素涂抹口腔患处。
●制霉菌素能抑制白色念珠菌的生长和繁殖,是鹅口疮的常用药物。
●建议使用制霉菌素混悬液,但是国内有的是制霉菌素片,没有配好的溶液。所以,需要自己配(某些高端私立医院可以提供配置好的,比如我们育学园儿科诊所)。制霉菌素基本不溶于水,但比较容易溶于油脂,所以,可以把它碾成粉末后,放到甘油或者家里的食用油中配好。配成10万单位/ml的使用。
●配好的混悬液,要放冰箱冷藏保存,否则会失效。
●在孩子吃奶、吃饭后用该药物涂抹孩子口腔,这倒不是怕药物被吃到孩子肚子里,因为这个药物吃后也基本不会吸收,会随着大便排除体外,而是为了让药物尽可能在口腔内多留一会。在口腔处作用时,也不会经粘膜吸收入血,所以,也不用担心药物过量影响孩子。
●对于新生儿(小于28天的宝宝),每次使用1 ml,分成两份,分别涂抹两侧口腔,白斑处一定要涂抹全,如果量不够,可以加量,反正也不吸收,该药每天使用4次,孩子症状多在几天内能见到效果,比如范围减小,孩子愿意吃奶了等等。但是药物一定要使用到症状消失后2天,大约2周左右,如果很快见效,也建议至少使用10天,不能见好就停,否则会反复!
●对于婴儿(大于28天,小于1岁的孩子),每次使用2 ml,分成两份,分别涂抹两侧口腔,每天使用4次,疗程同上。
●对于大于1岁的孩子,如果是轻度的鹅口疮,就是鹅口疮占整个口腔面积的50%以下,没有深部的感染,首选制霉菌素治疗。每次4-6 ml,分成两份,分别涂抹两侧口腔,每天使用4次,疗程同上。

2.氟康唑口服
氟康唑有抑制和杀灭白色念珠菌的作用,口服不受食物影响,吸收完全,之后进入各种体液和皮肤,在皮肤中的浓度比血液中还要高,所以口服该药物治疗口腔或皮肤念珠菌病非常有效。其总体治疗效果比制霉菌素好,严重的,制霉菌素治不好的,都用这个。
●对于大于1岁的孩子,如果是鹅口疮程度大于轻度,建议口服氟康唑,第1天每次6 mg/kg,一日1次,之后每次3 mg/kg,一日1次,每日最大剂量200 mg,使用到没有症状后2天,大约7-14天。
●所有孩子,在使用制霉菌素没有效果时,都可以直接口服氟康唑,使用方法同上。
碳酸氢钠能不能使用?
在国内经常有医生会开些5%碳酸氢钠,给孩子涂抹口腔,用以治疗鹅口疮,往往效果也不错。这是因为白色念珠菌最适合的生存环境时PH5.5左右,是弱酸环境,而使用碳酸氢钠后,处于碱性环境,抑制其生长。
但是,因为白色念珠菌在感染时,处于菌丝相,而菌丝相在中性或者碱性环境下都能生存的,所以,有时会发现使用碳酸氢钠对治疗鹅口疮效果不佳。并且,如果使用碳酸氢钠的浓度不对的话,可能加重鹅口疮。
所以,目前,不推荐单独使用碳酸氢钠,可以在使用制霉菌素前,用碳酸氢钠冲洗或者擦洗下口腔,之后再涂上制霉菌素,这样是可行的。不用行不行,当然行。
对孩子使用了抗真菌药物之后,孩子好了,但是过了几天,孩子又犯了,这可怎么好,什么原因导致的呢?
这是因为您只把孩子嘴里的真菌给消灭了,但是孩子嘴巴能接触的,其他地方的白色念珠菌还存在的,孩子再去接触这些地方,那就会再次感染,可不是就反复了。
孩子嘴巴接触的地方有:玩具,安抚奶嘴,奶瓶,妈妈的奶头,这是最关键的地方,嘴巴里的真菌沾染到这些地方,之后再沾染回去,导致循环感染。其他要注意的是妈妈的内衣,因为乳头和内衣会互相传。把这些都好好消毒,那才能不让孩子病情反复。
另外,如果孩子体内菌群长期紊乱,体内的好菌少,那么这次治疗好之后,白色念珠菌还是处于强势地位,还会继患病。
出现鹅口疮,家里怎么消毒?
白假丝酵母菌对于热的抵抗力不强,60摄氏度,加热1小时会杀灭。对干燥、阳光、紫外线、酒精等抵抗力较强。
所以,能煮的玩具、奶瓶、安抚奶嘴,就煮吧,煮完晾干。每次喂完奶后,使用制霉菌素涂抹妈妈的奶头,也要每日3-4次左右。妈妈的内衣,也要使用高温烫洗的方式清洗。

以上做好,基本就够了,其他地方无需使用制霉菌素涂抹,如果实在不放心,可以使用5%碳酸氢钠(也就是小苏打水)消消毒,多数有些效果。
益生菌有效果吗?
有效果。目前有系统综述和临床试验证明,使用益生菌,尤其是乳酸杆菌,对降低新生儿、老年人口腔白色念珠菌感染是有好处的。这些益生菌通过拮抗、竞争、免疫学作用,自己生长,抑制白色念珠菌生长,从而达到治疗的效果。
并且临床上,我们也发现使用益生菌可以治疗鹅口疮,并且是反复发作的、使用制霉菌素涂抹的也不好的鹅口疮。
有时我们说使用益生菌调理体内的菌群是是修炼内功,基础打好了,就不怕这点小风雨了,念珠菌一猖獗,分分钟教他做人。

我们抽烟、我们纹身,但我们是好菌!
所以,孩子出现鹅口疮时,使用益生菌2周到1月,尤其是乳酸杆菌是有益的。
鹅口疮会传染吗?
健康的孩子,接触点白色念珠菌,也不会感染,所以,小朋友们玩耍是没有问题的,但是不要让孩子们互相咬对方的玩具,不要吃对方的口水哦。

看着很美好,但是不要这样做!
如果孩子生病了,身体比较弱,那就不要和鹅口疮患儿一起玩耍了。
●自己要强壮:呵呵,吃的好,运动好,按时接种各种疫苗,身体就会强壮,这个自己去体会。
●菌群来帮忙:平时多接触各种细菌、病毒,建立起自己的协调的菌群,这个需要平时“脏点”,多接触大自然,平时家里不要总是用消毒剂消毒,少用湿巾,多接触各种菌,完善自己的菌群库,白色念珠菌就翻不起来浪了。

●减少孩子吃手指,含奶瓶,吃安抚奶嘴的时间。孩子长期的这样做,会不断刺激宝宝娇嫩的口腔粘膜,导致其损伤,那口腔局部的免疫力就会降低,就容易患鹅口疮。

减少安抚奶嘴使用时间
医生拔高-鉴别诊断
下面这个不是鹅口疮啊,而是口腔黏膜白斑病(oral leukoplakia)。

图片来自梅奥诊所
大家可以看到,这种粘膜白斑,是平的,有种角化的感觉,和鹅口疮的乳凝快的表现还是有明显区别的。这种粘膜多出现在舌两侧,牙龈、面颊内侧。
这种粘膜白斑和长期的外来刺激有关,比如长期吸烟、喝酒,嘴巴不停一直咀嚼等,有时牙齿位置不正确,或者假牙不适合,总是摩擦面颊也会导致这种问题。
粘膜白斑在少部分情况下,有癌变的可能,所以,如果这种白斑在停止上面说的各种刺激后,还持续大于2周,需要去医院皮肤科检查治疗。